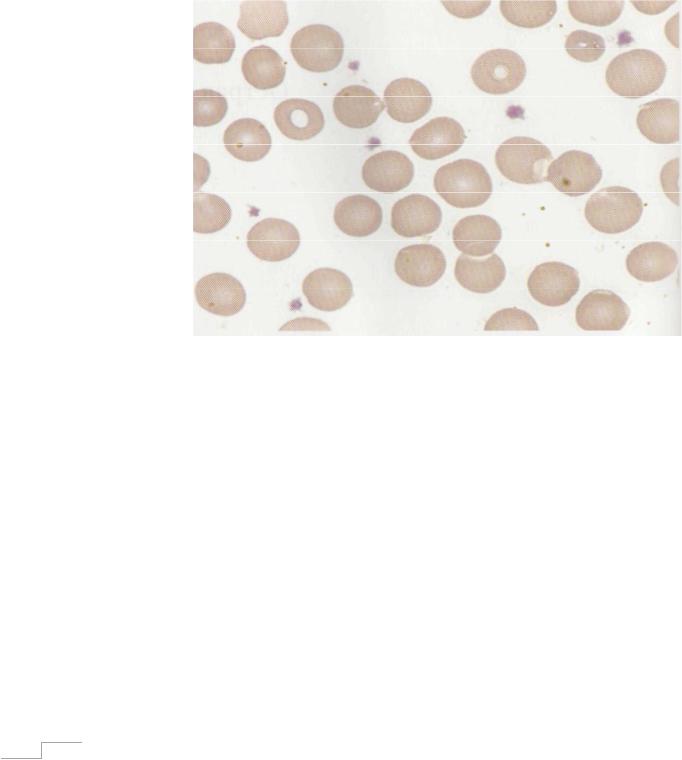
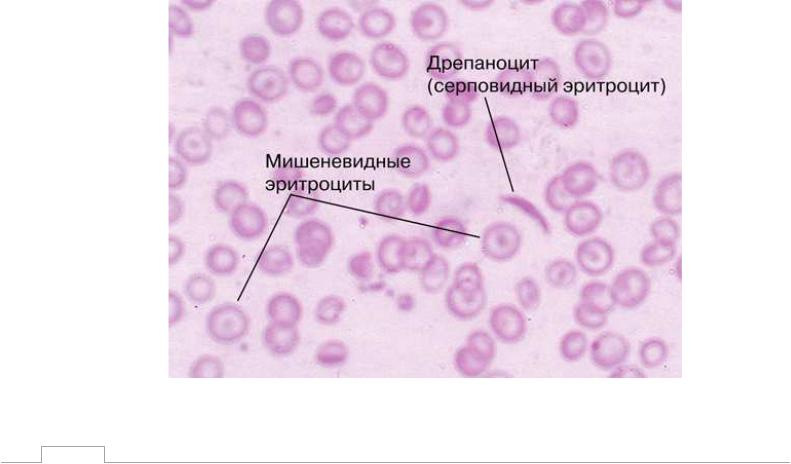
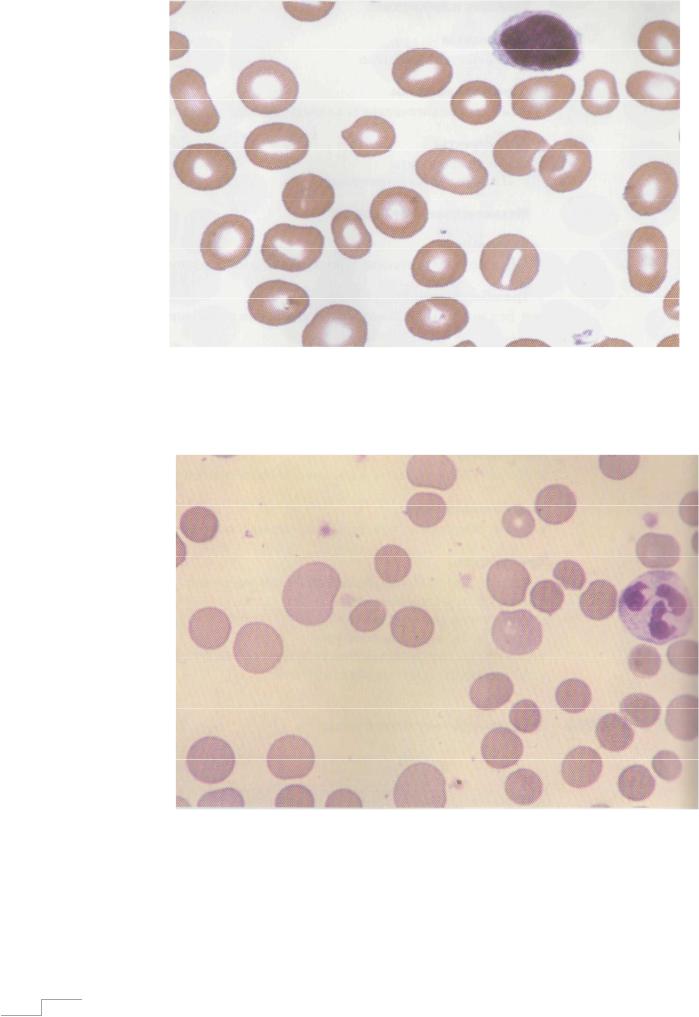

Материал: blood4
ситуацию на фоне выраженной вазоконстрикции и снижения объема циркулирующей крови. Позже, когда благодаря проводимой инфузионной терапии и адаптационным механизмам организма объем циркулирующей крови удается восстановить, показатели крови начинают отражать истинную картину последствий кровотечения – выраженную нормохромную норморегенераторную анемию. Изменения со стороны других ростков отсутствуют, либо может наблюдаться тромбоцитопения, лейкопения
(рис.10).
Рисунок 10. Мазок крови при анемии вследствие острой кровопотери.
В течение последующей недели, в восстановительном периоде острой постгеморрагической анемии, в гемограмме возможно обнаружить следствие гиперрегенерации процессов костономозгового кроветворения. Проявляется это ретикулоцитозом, тромбоцитозом, лейкоцитозом со сдвигом формулы влево на фоне сохраняющейся нормохромной анемии. Подобные изменения в совокупности расцениваются как благоприятный признак, отражающий адекватную реакцию организма на острую кровопотерю.
Что касается лечения данного состояния, то основные усилия первично должны быть направлены на купирование гиповолемического шока. В
45

случае, если анемический синдром носит резко выраженный характер,
необходимо проведение заместительной терапии эритроцитсодержащими средами. Учитывая повышенную потребность в железе при выраженной активации кроветворных ростков, в данный период возможно назначение препаратов железа. Особенно это актуально при наличии латентного, либо прелатентного дефицита железа на момент развития острой кровопотери.
При удовлетворительных запасах железа в депо, в назначении препаратов железа необходимости нет.
Контрольные задания к разделу III.1
1.Какая кровопотеря называется острой?
2.В какой период после острой кровопотери формируется острая постгеморрагическая анемия?
3.Как выглядит гемограмма больного сразу после остановки кровотечения, приведшего к острой кровопотере?
4.Предложите терапевтическую тактику острой постгеморрагической анемии тяжелой степени с выраженной клинической картиной анемического синдрома.
5.Требуется ли назначение препаратов железа пациентам с острой постгеморрагической анемией? Каковы опорные критерии необходимости подобного назначения?
46

III. 2 Гемолитические анемии
Гемолитические анемии включают в себя достаточно разнородную по этиологическим факторам группу заболеваний, в основе патогенеза которых лежит патологический гемолиз – процесс разрушения эритроцитов,
превышающий возможности организма компенсировать эти потери. В
зависимости от топики гемолиза описываемые анемии подразделяются на:
-анемии с внутрисосудистым гемолизом (гемолиз реализуется в кровяном русле);
-анемии с внутриклеточным гемолизом (процесс происходит в ткани селезенки, печени, костного мозга, в макрофагах и при хроническом течении обуславливает спленомегалию и\или гепатоспленомегалию)
Классификация гемолитических анемий:
I. ВРОЖДЕННЫЕ ГЕМОЛИТИЧЕСЧКИЕ АНЕМИИ
1.Протекающие с нарушением цитоскелетных белков мембран эритроцитов
-Наследственная сфероцитарная анемия (наследственный сфероцитоз)
-Наследственный эллиптоцитоз
-Наследственный акантоцитоз
2.Энзимопатии
-С патологией активности ферментов гликолитического цикла в эритроцитах
-С патологией в метаболизме нуклеотидов
-С патологией ферментов пути ЭмбденаМейергофа
3.Гемоглобинопатии
-Серповидно-клеточная анемия (рис.11)
-Талассемия (относится к гипохромным анемиям) (рис.3)
-Гемолитическая анемия, обусловленная нестабильными гемоглобинами
4.Ночная пароксизмальная гемоглобинурия
(болезнь Маркиафавы – Микели) (рис.12)
47
II. ПРИОБРЕТЕННЫЕ ГЕМОЛИТИЧЕСЧКИЕ АНЕМИИ
1.Иммунные гемолитические анемии (рис. 13)
-Аутоиммунная гемолитическая анемия
∙с несколькими тепловыми агглютининами
∙с тепловыми гемолизинами
∙с полными холодовыми агглютининами
∙с холодовыми двухфазными гемолизинами
Из приведенной классификации становится ясным многообразие причин,
приводящих к гемолизу (аномалия клеточной стенки эритроцита,
гемоглобина, ферментных систем, воздействие различных антител,
химических и физических агентов). В данном разделе мы не будем останавливаться на каждой из указанной в классификации нозологии,
поскольку в задачи терапевта (врача общей практики) не входит установление конкретной причины гемолиза. Тем не менее, крайне важным представляется верификация самого этого процесса и постановка диагноза гемолитической анемии как таковой. Ввиду этого мы подробно рассмотрим клинические и лабораторные проявления гемолиза, при выявлении которого,
пациента незамедлительно следует направить на консультацию к гематологу.
Рисунок 11. Мазок крови при серповидноклеточной анемии.
48
Рисунок 12. Мазок крови при болезни Маркиафавы – Микели
Рисунок 13. Мазок крови при иммунной гемолитической анемии. Наблюдаемый сфероцитоз связан с внутрисосудистым характером гемолитического процесса.
49